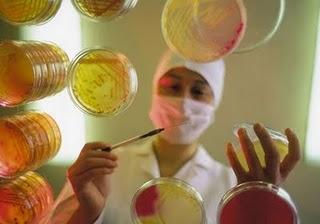
wallpaper-1689754

Gedankenlesen per Hirnscan
Mai 17, 2011
Urzeit

Ernst Probst ist Autor von mehr als 100 Büchern, Taschenbüchern, Broschüren, Museumsführern und E-Books
Meine Blogs
Internet-Zeitung
Die Artikel des Blogs Internet-Zeitung wurden 310 mal geteilt
Interview-Weblog
Die Artikel des Blogs Interview-Weblog wurden noch nicht geteilt
natur-news
Die Artikel des Blogs natur-news wurden noch nicht geteilt